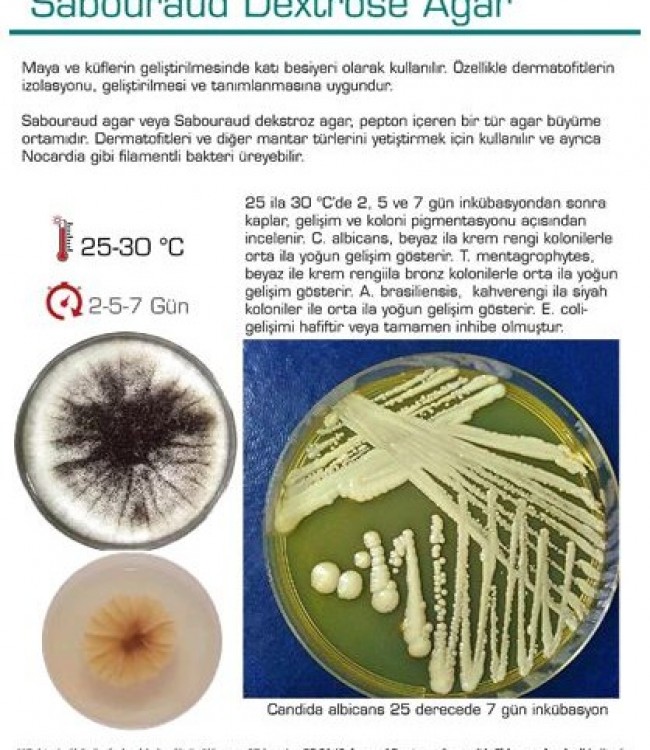
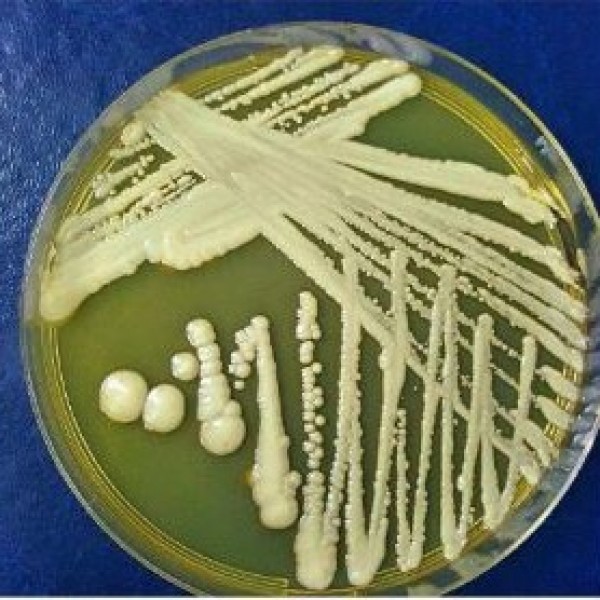

Sabouraud Dextrose Agar
Sabouraud Dextrose Agar
Maya ve küflerin geliştirilmesinde katı besiyeri olarak kullanılır. Özellikle dermatofitlerin izolasyonu, geliştirilmesi ve tanımlanmasına uygundur.
Sabouraud agar veya Sabouraud dekstroz agar, pepton içeren bir tür agar büyüme ortamıdır.
Dermatofitleri ve diğer mantar türlerini yetiştirmek için kullanılır ve ayrıca
Nocardia gibi filamentli bakteri üreyebilir.
25 ila 30C'de 2,5 ve7 gün inkübasyondan sonar kaplar, gelişim ve koloni pigmentasyonu açısından incelenir.
C. albicans, beyaz ila krem rengi kolonilerle orta ile yoğun gelişim gösterir.
T. mentagrophytes, beyaz ile krem rengiila bronz kolonilerle orta ila yoğun
gelişim gösterir.
A. brasiliensis, kahverengi ila siyahkoloniler ile orta ila yoğun gelişim gösterir.
E. coli gelişimi hafiftir veya tamamen inhibe olmuştur